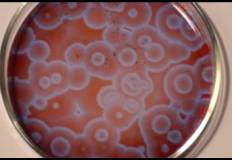

Технические науки/ 2.Механика
Ольховская Е.П.,
Давыденко М.В.
ГБПОУ Краснодарского
края «Пашковский сельскохозяйственный колледж»
Гармония хаоса и порядка. Построение примера механической
самоорганизующейся системы.
Все системы в природе стремятся к равновесию.
Однако, если исключить часто встречающийся, но неинтересный крайний случай
безразличного равновесия - раскрученная пружина, упавший камень, то придется
признать: это стремление систем постоянно остается неудовлетворенным - огромное большинство состояний неравновесны.
А это значит, что, достигнув равновесия, система переходит от большего числа
состояний к меньшему. То есть она совершает выбор в том смысле, что некоторые
состояния ею отвергаются - те, что она покидает, а некоторые сохраняются - те,
в которые она переходит.
Целью данной работы стало желание ознакомить
окружающих с понятием синергетики заставить задуматься над вопросом «А все ли
на свете происходит хаотично?», а также продемонстрировать пример механической
самоорганизующейся системы. Авторы выдвигают гипотезу о том, что все процессы в
жизни, природе, технике происходят не случайно.
Объект изучения синергетики, независимо от его
природы, обязан удовлетворять следующим требованиям: 1) открытость -
обязательный обмен энергией и (или) веществом с окружающей средой; 2)
существенная неравновесность - достигается при определенных состояниях и при
определенных значениях параметров, характеризующих систему, которые переводят
ее в критическое состояние, сопровождаемое потерей устойчивости;
3)
выход из критического состояния скачком, в процессе типа фазового перехода, в
качественно новое состояние с более высоким уровнем упорядоченности.
Самоорганизующиеся системы обретают присущие им
структуры или функции без какого бы то ни было вмешательства извне. Обычно эти
системы состоят из большого числа подсистем. При изменении определенных
условий, которые называются управляющими параметрами, в системе образуются
качественно новые структуры. Эти системы обладают способностью переходить из
однородного, недифференцированного состояния покоя в неоднородное, но хорошо
упорядоченное состояние или в одно из нескольких возможных состояний.
Самоорганизующиеся системы способны сохранять внутреннюю
устойчивость при воздействии внешней среды, они находят способы самосохранения,
чтобы не разрушаться и даже улучшать свою структуру.

Ячейки Бенара. Для поддержания ячеистой структуры в
жидкости требуется подвод (снизу) и отвод (сверху) тепла. Другим примером из
гидродинамики является возникновение тороидальных вихрей Тейлора между
вращающимися цилиндрами.
Реакция Белоусова-Жаботинского. В химии примером
является реакция Белоусова-Жаботинского, представляющая собой периодическую
химическую реакцию, сопровождающуюся периодическим изменением цвета реакционной
смеси. Эту пульсирующую реакцию еще называют химическим маятником. Указанные
химические процессы и реакции лежат в основе жизни. Построение механической самоорганизующейся
системы. В качестве примера механической самоорганизующейся системы
была выбрана установка, состоящая из 15 математических маятников. Маятники
подвешены на нитях длиной от 21,2 до 34,4 см, которые были вычислены с помощью
формулы периода математического маятника в электронных таблицах EXСEL. Самый длинный
совершает 51 колебание в минуту, самый короткий 65.
0Приведем несколько фотографий процесса движения совокупности
математических маятников. На них видно, что сначала шарики выстраиваются в одну
волну, затем разбиваются на 3 и 2 волны, в промежутках, шарики выстраиваются в
2 и 3 шеренги. Затем снова все возвращается к 1 волне.
Данная система полностью удовлетворяет всем параметрам, необходимым для
названия ее именно самоорганизующейся. Актуальность и практическая ценность данной
установки заключается в следующем: можно и нужно использовать как наглядную
демонстрацию зависимости периода колебаний от длины подвеса; на дополнительных,
факультативных, кружковых занятиях по физике; на занятиях по естествознанию у
студентов специальностей нетехнического профиля; в качестве наглядного примера системы, члены которой не зависимы
друг от друга, а в процессе движения организуют четкие структуры, на занятиях
по философии, политологии; для
популяризации науки, представления на конференциях и семинарах.
ЛИТЕРАТУРА
1. Самоорганизующиеся системы, пер. с англ. М., 1964;
2. Принципы самоорганизации, пер. с англ. М., 1966;
3. Эйген М., Винклер Р. Игра жизни, пер. с нем. М., 1979;
4. Николис Г., Пригожин И. Самоорганизация в неравновесных системах, пер. с
англ. М., 1979;
5. Пригожин И. От существующего к возникающему, пер. с англ. М., 1985;